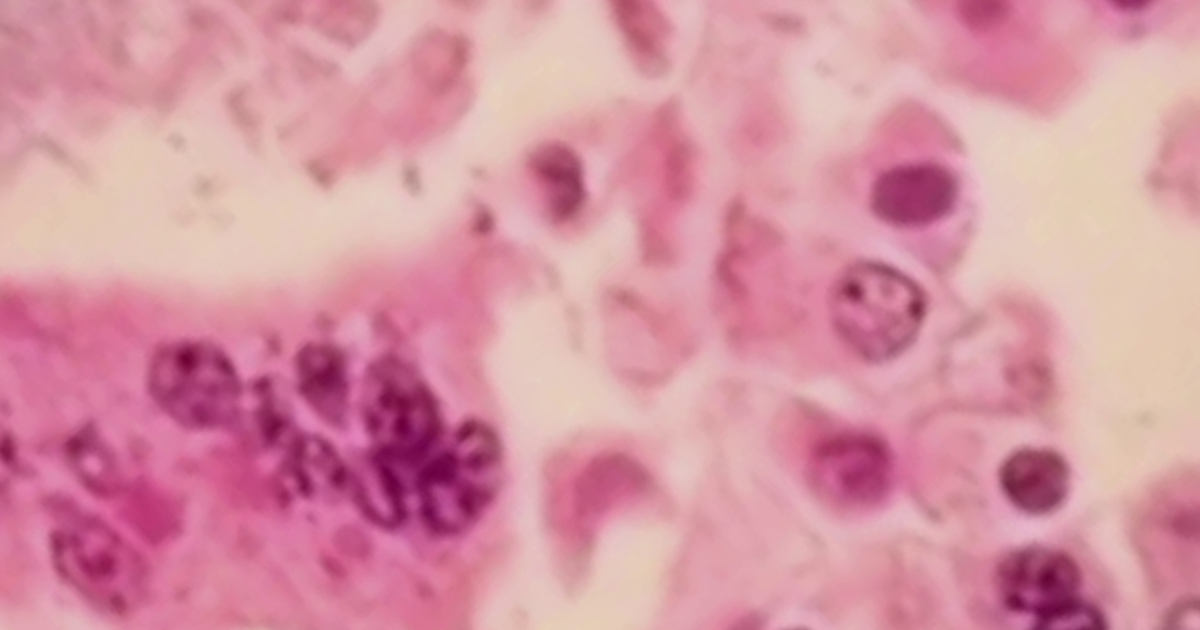
Measles outbreak in Michigan county as cases spread 'like wildfire'

Measles outbreak in Michigan county as cases spread 'like wildfire'
Key Points:
- Washtenaw County officials have confirmed three measles cases since March 12, all linked to travel from Florida, with no known exposure sites in Michigan.
- The Michigan Department of Health and Human Services warns that measles transmission risk is increasing, especially following spring break travel, due to the highly contagious nature of the virus.
- Health experts emphasize that the MMR vaccine remains the most effective protection, with two doses providing 97% immunity against measles.
- Since January, over 1,350 measles cases have been reported across 31 states, while vaccination rates in Michigan have declined in the past year.
- Local health officials urge vaccination to contain the outbreak and protect vulnerable populations such as young children, immunocom













